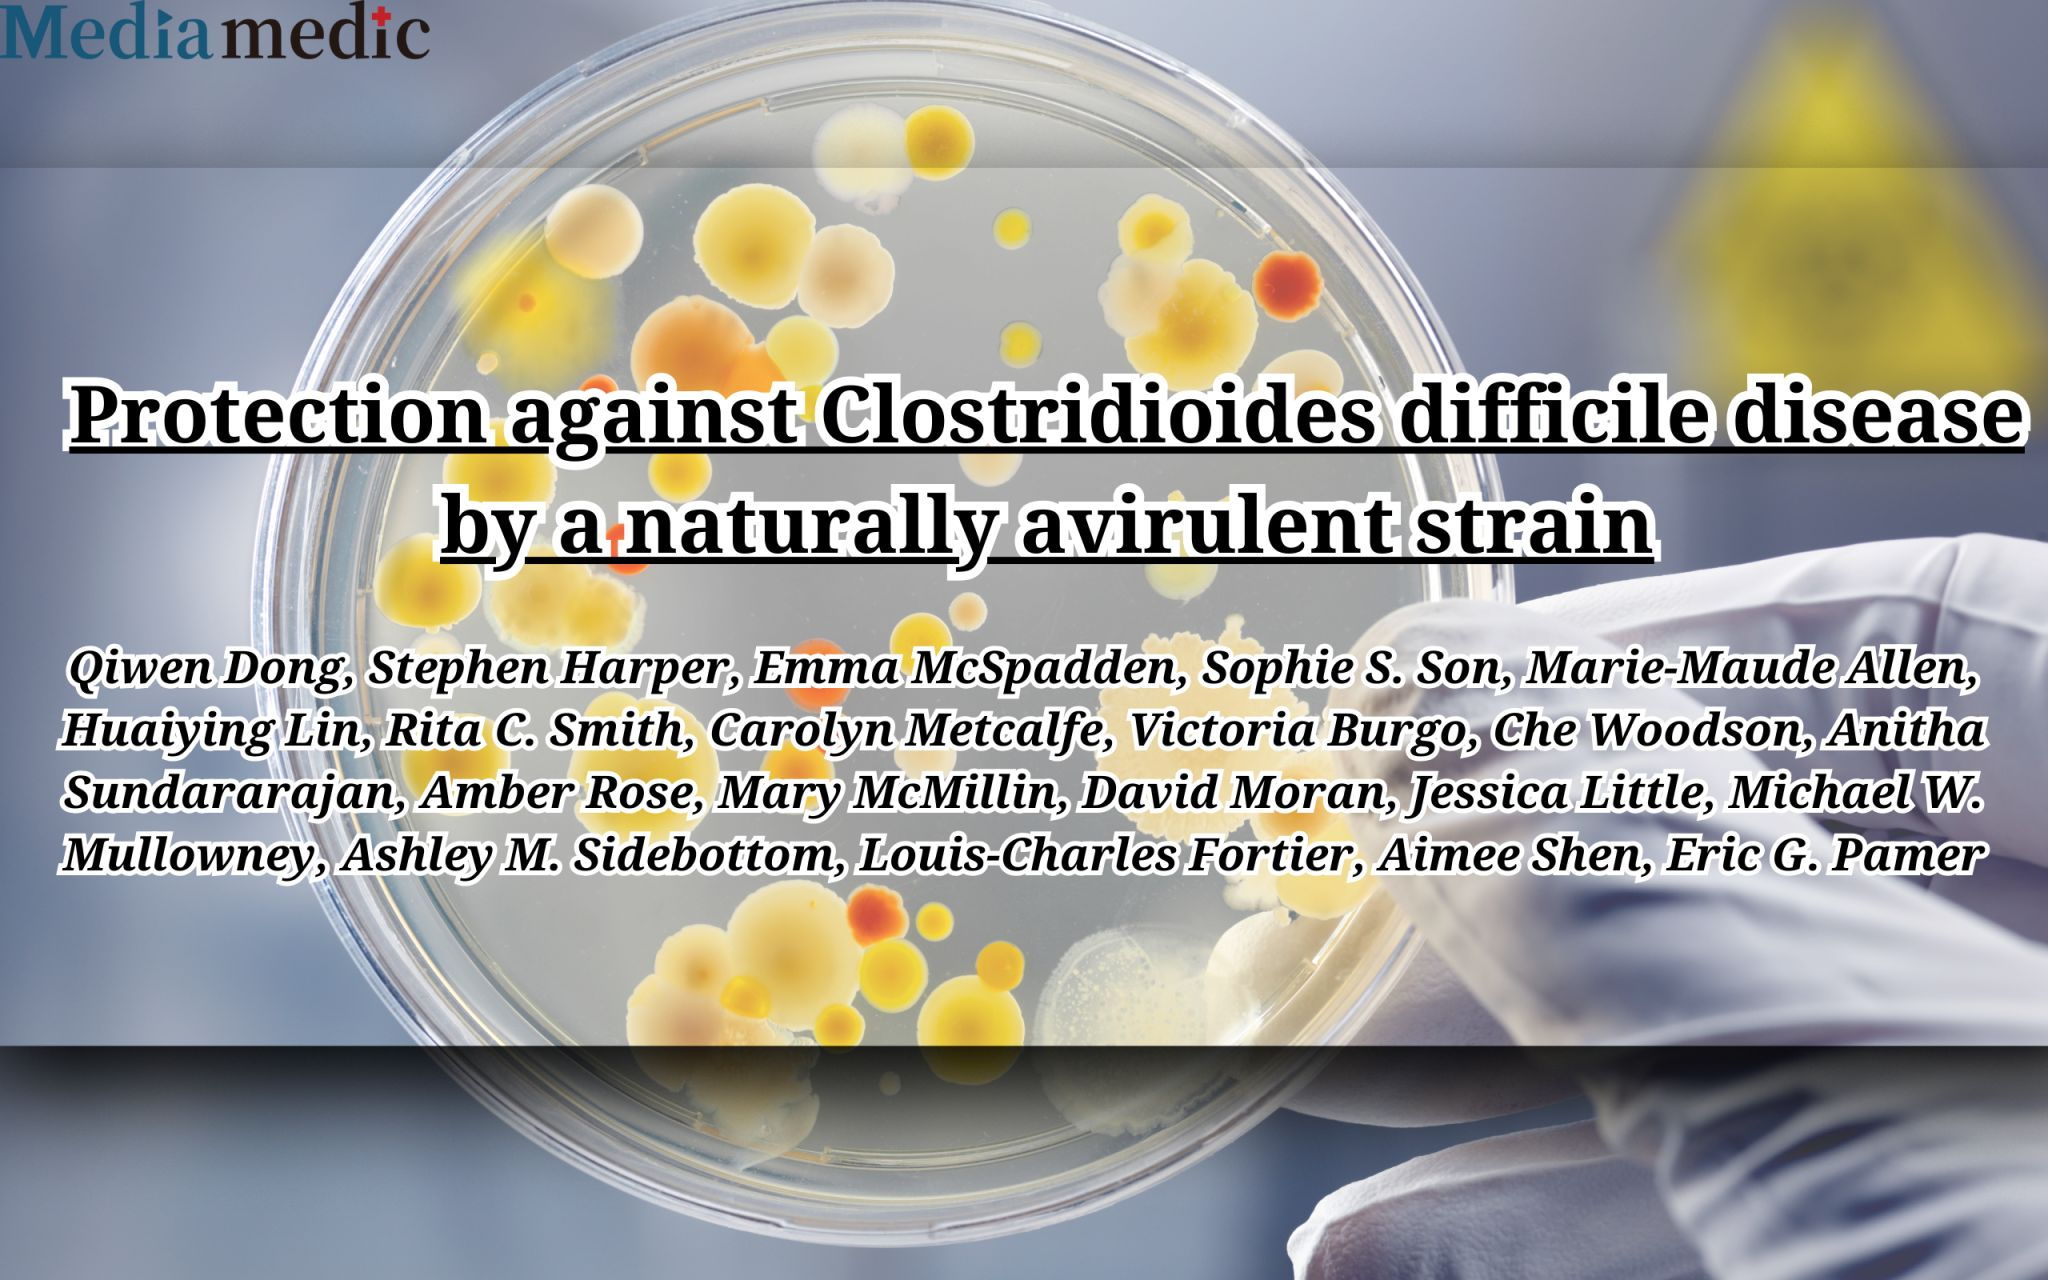
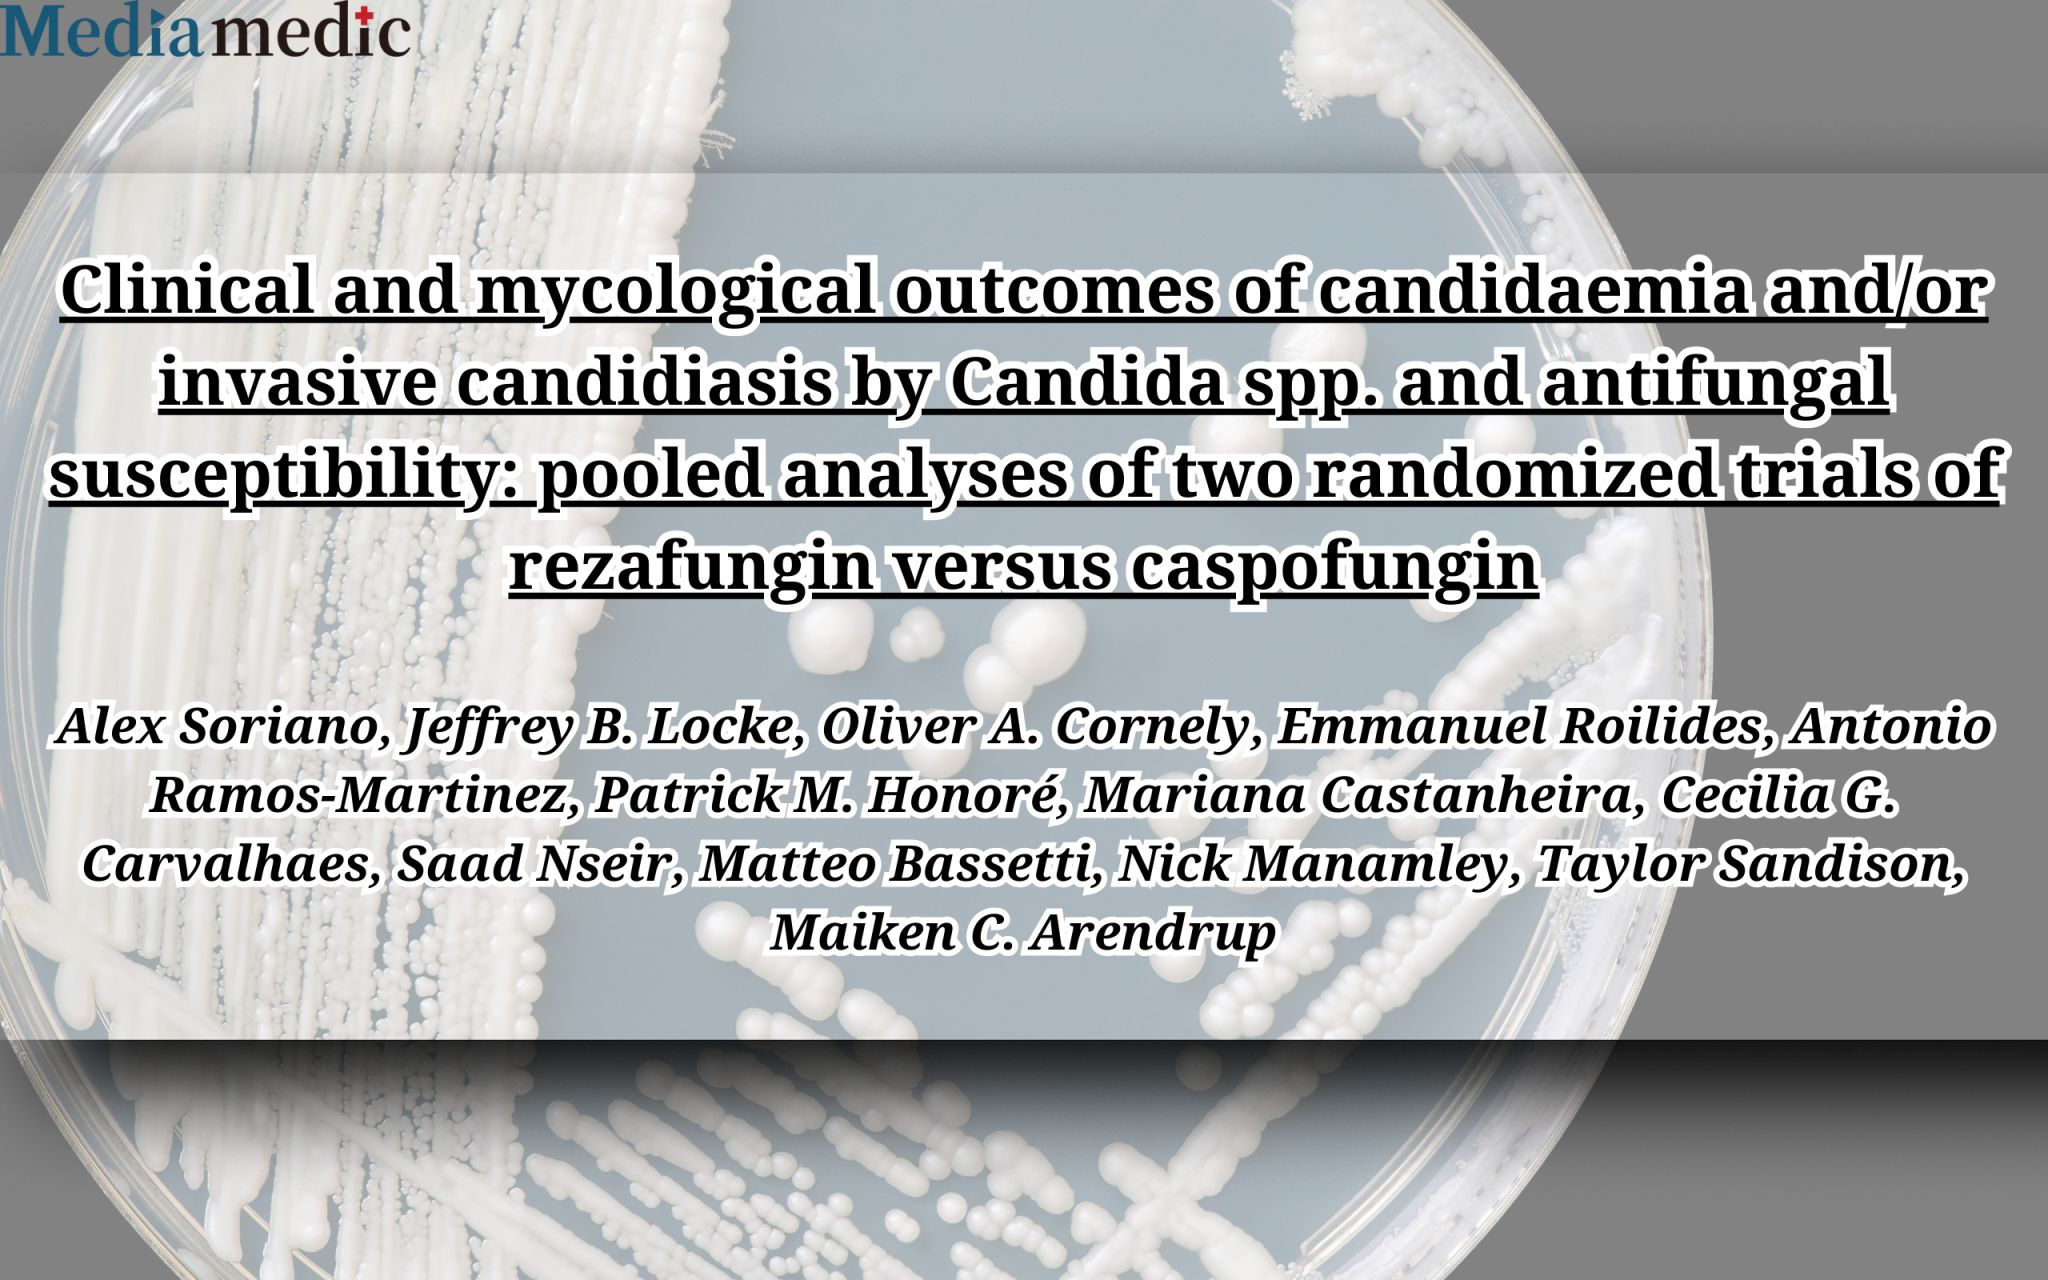

-

Optimizing First-Line Treatment for Advanced Biliary Tract Cancers: Insights from the Journal of Clinical Oncology
In January 2025, the Journal of Clinical Oncology published an important Grand Rounds article titled “Finding the Right Partner: Triplet Therapy for First-Line Advanced Biliary Tract Cancers.”This piece delves into…
-

The Freiburg Index of Post-TIPS Survival (FIPS): A Key Predictor for Decompensation and ACLF Risk
In February 2025, the Journal of Hepatology published a pivotal study revealing how the Freiburg Index of Post-TIPS Survival (FIPS) can effectively identify patients at high risk of further decompensation…
-

Pneumococcal Pneumonia Trends in Adults: A Decade of Shifting Patterns (2013–2023)
A recent study published in BMJ Thorax highlights significant changes in the landscape of pneumococcal pneumonia among adults hospitalized with community-acquired pneumonia (CAP) over the past decade. The data, drawn from a prospective cohort of over 5,000 patients, reveals that the proportion of CAP cases caused by pneumococcus has nearly doubled, rising from 36.4% in…
-

Exploring the Potential of Cefepime-Enmetazobactam Against Carbapenem-Resistant Gram-Negative Bacteria
Antimicrobial resistance remains one of the biggest threats to global health. A recent study published in Clinical Microbiology and Infection evaluates the in vitro activity of cefepime-enmetazobactam, a novel β-lactam/β-lactamase inhibitor combination, against carbapenem-resistant Gram-negative pathogens.
-

Rethinking Antibiotic Strategies: The Oral vs. IV Debate in Severe Infections
In the world of inpatient infectious disease (ID) consults, a recurring challenge surfaces: the hesitation to shift from IV to oral antibiotics, even when clinical evidence supports it. This dialogue between an ID consultant and a surgeon, as shared by Dr. Paul Sax in NEJM Journal Watch, perfectly illustrates the tension.
-

Impact of Pneumosil Mass Campaigns on Reducing Pneumococcal Carriage in Niger: Promising Results from a Cluster-Randomised Trial
Valuable researchers have conducted a groundbreaking three-arm, open-label, cluster-randomised trial in Niger to evaluate the effectiveness of mass campaigns using full and fractional doses of the pneumococcal conjugate vaccine (Pneumosil, PCV10) in reducing nasopharyngeal pneumococcal carriage among children aged 1–9 years.
-
A New Hope in Preventing Clostridioides difficile Infections: The Power of a Naturally Avirulent Strain
Valuable researchers have uncovered promising insights into combating Clostridioides difficile infection (CDI), a leading cause of healthcare-associated infections. The study reveals that a naturally avirulent C. difficile strain, ST1-75, can protect against CDI by outcompeting virulent strains such as R20291.
-
Exploring Effective Treatments for Invasive Candidiasis: Insights from Recent Research
A recent analysis sheds light on the clinical and mycological outcomes of treating candidaemia and invasive candidiasis with rezafungin compared to caspofungin. This study, pooling data from the STRIVE and ReSTORE trials, evaluated the efficacy of once-weekly rezafungin versus daily caspofungin across various Candida species. The findings suggest that rezafungin offers comparable, and in some…
